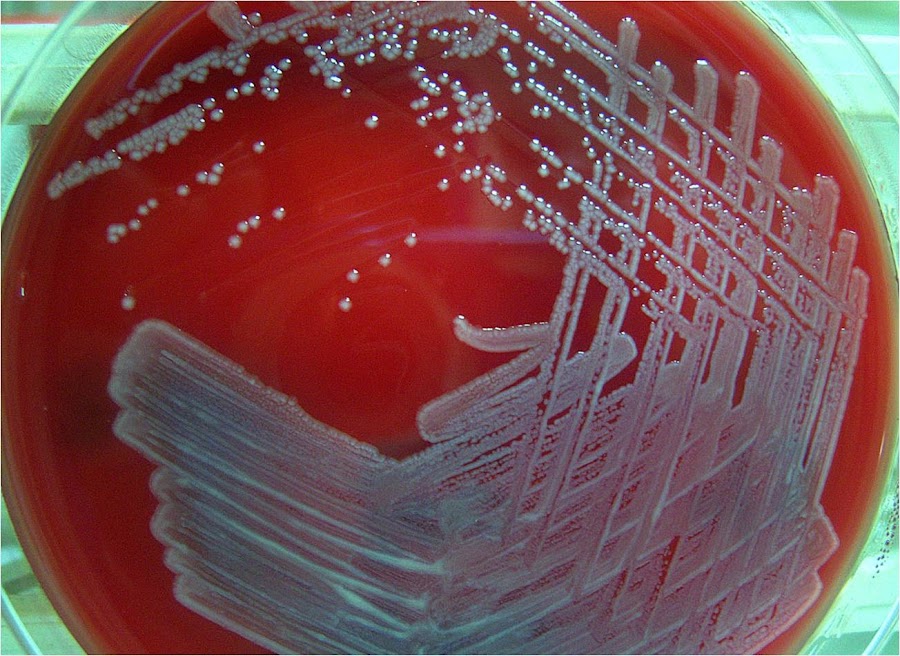

(Buda)
Las Enterobacterias (Última Parte)
Género Morganella
Morganella, pertenece a la familia Enterobacteriaceae y hasta el momento, presenta una sola especie: morganii. Inicialmente, Morganella morganii recibió el nombre de Proteus morganii, pero por estudios genéticos, se le sacó del género Proteus y se creó el género Morganella. Este último género, presenta un INVIC: + + - - , es capaz de hidrolizar la urea, tiene una movilidad variable a 37° C y produce ácido y gas a partir de la glucosa. Además, es capaz de reducir los nitratos a nitritos, de fermentar la manosa y como todos los integrantes de la familia Enterobacteriaceae, es oxidasa negativa.
Las cepas de Morganella morganii, crecen bien en los medios de aislamiento primarios como el agar sangre y el agar MacConkey, no son hemolíticas y usualmente no producen el fenómeno de "swarming" como Proteus. En épocas recientes, se propuso la creación de una sub clasificación de este género en dos sub especies: Morganella morganii ssp. morganii y Morganella morganii ssp. sibonii. M. morganii, es causa conocida de infecciones del tracto urinario y fuera del tracto urinario, puede producir diversos tipos de infecciones. Por otra parte, se le ha relacionado como un patógeno entérico, sin embargo, aquí, su papel etiológico es dudoso. En forma reciente, se documentó un caso de una corioamnionitis y sepsis asociada, caso complicado con un síndrome de distress respiratorio, además de infecciones en el recién nacido.
Este agente, rara vez es causa de infecciones invasivas en personas inmunocompetentes, pero sí puede ser una causa probable de infecciones nosocomiales en personas inmunocomprometidas. Esta bacteria, presenta una resistencia intrínseca a la polimixina, ampicilina y a cefalotina y se ha documentado que es capaz de producir una beta lactamasa inducible o la beta lactamasa de efecto expandido. Todo esto, claro está, cuando el agente se ve expuesto a un agente inductor y las enzimas producidas, hidrolizan a las penicilinas y cefalosporinas de efecto expandido. Generalmente, estas bacterias dejan de producir la enzima cuando el agente inductor es removido, aun cuando, algunas cepas mutan a un estado de continua producción de beta lactamasa. Todo esto nos habla de un agente con una alta resistencia antimicrobiana, tanto natural (intrínseca) como adquirida.
Género Providencia
Providencia rettgeri (antes Proteus rettgeri) es una bacteria móvil perteneciente al género Providencia, que junto a Proteus y Morganella forman la tribu Proteae o Pro. Componente normal de la flora colónica en el hombre, se diferencia de otras especies de Providencia en que hidroliza rápida y abundantemente la urea pero no metaboliza a la lactosa como los otros integrantes de Enterobacterias. Como patógeno humano se ha descripto como causante de infecciones urinarias, sobre todo en pacientes mayores y con catéteres uretrales, y en infecciones de heridas en pacientes inmunodeprimidos y quemados. A diferencia de P. stuartii son muy escasas las publicaciones de bacteriemias causadas por este microorganismo. En una revisión bibliográfica en PubMed utilizando los términos Bacteriemia y Providencia rettgeri aparecen sólo 2 casos de sepsis fatal en probable relación a contaminación de hemoderivados y algún caso aislado en grandes series de bacteriemias.
Por otra parte, Providencia alcalifaciens es un miembro bastante semejante al anterior y perteneciente también a la familia Enterobacteriaceae. Hay informes que P. alcalifaciens puede causar diarrea, pero el mecanismo por el que la causa no es bien conocido. El modelo de condensación de la actina era diferente del producido por la toxina enteropatogénica de Escherichia coli pero similar a Shigella flexneri. Se concluye que algunas algunas subespecies de P. alcalifaciens son los enteropatogénicos y que ellos causarían los cuadros de diarrea invadiendo el epitelio de la mucosa intestinal.
Género Yersinia
Este género comprende varias especies entre ellas Yersinia pestis, agente de la Peste Negra o Plaga Bubónica o Neumónica, comúnmente llamada la Muerte Negra, enfermedad de los roedores, transmitida ocasionalmente al hombre por las pulgas, con pandemias históricas desde el siglo VI, donde mató a un tercio de la población en Europa. Luego de la Edad Media ha habido brotes en diversas partes del mundo, sobre todo en relación con las guerras. Se han denunciado en 1995 y comienzos de 1996 casos en India, Madagascar y otros países africanos, en Brasil y Perú. Y. pestis es endémica en algunas regiones tales como Irán y el oeste de Estados Unidos. Otra especie, Y. enterocolitica es muy ubiquitaria, se ingiere con agua o alimentos contaminados. Algunos biotipos están relacionados con enterocolitis en el hombre. Raramente presenta infecciones sistémicas. Sin embargo, las bacterias atraviesan con frecuencia la mucosa y se multiplican en los nódulos linfáticos mesentéricos. Debido a los intensos dolores abdominales el cuadro puede confundirse con apendicitis. Ocasionalmente puede haber una artritis reactiva 2 a 6 semanas luego de la infección. Esto se ve frecuentemente en pacientes con antígeno HLA-B27 de histocompatibilidad. Cepas virulentas de las 2 especies poseen al menos un gran plásmido de virulencia.
Y. enterocolitica es una bacteria pequeña de forma redonda y Gram-negativa, la cual es aislada frecuentemente de los especímenes clínicos tales como las heridas, las heces fecales, el esputo o las glándulas linfáticas mesentéricas. Sin embargo, no forma parte normal de la flora humana. Por otro lado, Y. pseudotuberculosis ha sido aislada del apéndice infectado en los humanos. Ambos organismos han sido aislados frecuentemente de los animales, tales como los cerdos, las aves, los castores, los gatos y los perros. Solamente la bacteria Y. enterocolitica se ha encontrado en muestras ambientales de lagunas y lagos, y en alimentos como la carne, los helados y la leche. La mayoría de los organismos aislados no han sido catalogados como patógenos. El nombre de la enfermedad causada por este microorganismo es yersiniosis.
Existen tres especies patogénicas dentro del género Yersinia, pero sólo Y. enterocolitica y Y. pseudotuberculosis causan gastroenteritis. Hasta el momento, se han reportado muy pocos casos de brotes causados por Y. pseudotuberculosis, como por ejemplo las presentadas en Japón, donde se reportaron infecciones en humanos transmitidas por alimentos y por aguas contaminadas. La yersiniosis se caracteriza generalmente por síntomas tales como la gastroenteritis con diarrea y/o con vómito; sin embargo, la fiebre y el dolor abdominal son los síntomas que la definen. Las infecciones causadas por Yersinia son similares a la apendicitis y a la linfadenitis mesentérica, pero esta bacteria también puede causar infecciones en otras áreas como en las heridas, en las articulaciones y en el tracto urinario.
La dosis infecciosa es desconocida. La aparición de la enfermedad se da entre las 24 y 48 horas después de la ingestión, la cual es la ruta usual de infección (los alimentos y las bebidas son los vehiculos de transmisión). El diagnóstico de la yersiniosis se inicia con el aislamiento del microorganismo a partir de las heces fecales, de la sangre, o del vómito de la víctima, y a veces la muestra es tomada durante la apendicectomía. La confirmación se realiza con el aislamiento y la posterior identificación bioquímica y serológica de Y. enterocolitica, provenientes tanto del hospedero humano como del alimento ingerido. Se ha reportado que la diarrea ocurre en el 80% de los casos; y que los síntomas más confiables son el dolor abdominal y la fiebre. Dada la dificultad para el aislamiento de yersiniae de las heces fecales, muchos países dependen de la serología. Para ello, a los pacientes críticos y convalecientes se les realiza un análisis en busca del serotipo de Yersinia spp. sospechoso.
Las cepas de Y. enterocolitica se pueden encontrar en las carnes (de cerdo, la de carne de vaca, la de cordero, etc.), en las ostras, el pescado, y la leche cruda. La causa exacta de la contaminación de los alimentos es desconocida. Sin embargo, la prevalencia de este organismo en el suelo y el agua, así como también en ciertos animales como los castores, los cerdos, los conejos y las ardillas, ofrece grandes oportunidades para que este organismo ingrese a la cadena alimentaria. La falta de higiene de los manipuladores de alimentos y las técnicas de esterilización inadecuadas, además del almacenamiento inapropiado, son también importantes fuentes que contribuyen a la contaminación. Yersinia es sensible al calor y como resultado morirá durante el calentamiento (mayor a 70°C). L as principales causas de infección son el consumo de los alimentos crudos o parcialmente cocidos y así como la contaminación cruzada, que ocurre cuando los productos cocidos entran en contacto con los materiales crudos o contaminados (tablas para cortar). Por esta razón, la cocción adecuada y la higiene en el manejo de los alimentos pueden prevenir las infecciones causadas por Yersinia en una gran medida. Las poblaciones más susceptibles a la enfermedad principal y a sus posibles complicaciones son las más jóvenes, también los débiles, los ancianos y las personas que se encuentren bajo terapias inmunosupresoras.
El nombre del género Yersinia viene dado por su descubridor, en 1894, Alexandre Yersin, bacteriólogo franco-suizo del Instituto Pasteur. Originalmente, este microorganismo fue denominado Pasteurella pestis, pero en el año 1967 fue renombrado como Yersinia pestis en honor a su descubridor. Yersinia pestis es un agente infeccioso que ha sido directamente responsable de más muertes humanas que cualquier otra enfermedad infecciosa, salvo la malaria. Ha originado diversas pandemias a lo largo de la historia, entre las que cabe destacar: la Plaga de Justiniano (541-542 dC), que asoló Asia, el norte de África, Arabia y parte de Europa; la Peste Negra (1347-1351 dC), que acabó con la vida de un tercio de la población de Europa; y la Tercera Pandemia (1855-1959), que comenzó en China e India y terminó por extenderse por el resto de Asia, África y América.
El papel de Y. pestis en la Peste Negra se ha debatido entre los historiadores; algunos han sugerido que la Peste Negra se propagó muy rápido para haber sido causada por Y. pestis. Se ha encontrado ADN de Y. pestis en los dientes de aquellos que murieron de Peste Negra pero, sin embargo, cadáveres medievales que murieron de otras causas no dieron positivo a Y. pestis. Esto sugiere que Y. pestis fue un factor que contribuyó a las plagas europeas, pero probablemente no el único. Es posible que las presiones selectivas inducidas por la plaga puedan haber cambiado el modo en que el patógeno se manifiesta en humanos, seleccionándose en contra de individuos o poblaciones que eran más susceptibles.
Yersinia pestis, agente de la denominada peste bubónica o peste negra, que asoló Europa a mediados del siglo XIV. Esta especie presenta tres subespecies: Y. pestis antiqua, Y pestis medievalis y Y. pestis orientalis.
Yersinia pseudotuberculosis, agente de una enfermedad parecida a la tuberculosis que afecta a los nódulos linfáticos en animales y raramente en humanos.
Yersinia enterocolitica, agente de ciertas infecciones intestinales (a veces también sistémicas) en humanos y animales.
A continuación se exponen los tres tipos de infecciones a las que puede dar lugar Yersinia pestis:
Peste bubónica: En el tipo de infección más común. Una vez que las células bacterianas han sido introducidas mediante la picadura de una pulga dentro de un ser humano, las células bacterianas se desplazan por el torrente sanguíneo hasta los nódulos linfáticos donde generan pequeñas hinchazones denominadas bubones, que están llenos de partículas bacterianas. La cápsula viscosa que rodea a las células de Y. pestis evita que estas sean fagocitadas por los macrófagos. En poco tiempo, los nódulos linfáticos periféricos se ven invadidos por bubones secundarios, hasta que se rompen y las células pasan de nuevo al torrente circulatorio, pero ahora en un número mucho más elevado, lo que causa una septicemia generalizada. En este estado, se producen múltiples hemorragias que dan lugar a manchas negras sobre la piel, procesos de gangrena en los extremos distales de las extremidades, fuerte dolor en nódulos linfáticos, postración, shock y delirio. Si la peste no es tratada antes del estado septicémico, la muerte sobreviene al cabo de 3-5 días.
Peste septicémica: Esta infección implica una rápida dispersión de Y. pestis por todo el cuerpo, a través del torrente circulatorio, sin tiempo para que se formen los bubones. La muerte suele sobrevenir en 1 día, por lo que habitualmente no da tiempo a ser diagnosticada.
Las células de Y. pestis producen ciertas moléculas antigénicas que contribuyen en mayor o menor medida al proceso de la enfermedad.
En la pared bacteriana se encuentran unos complejos de proteína-lipoproteína, denominados antígenos VW y F1, cuya función es evitar la fagocitosis por parte de los macrófagos y otras células fagocíticas.
Las cepas virulentas de Y. pestis producen y secretan una exotoxina denominada toxina murina (debido a su extrema toxicidad para el ratón), cuyo modo de acción se basa en inhibir la respiración, bloqueando las reacciones de transporte de electrones en las mitocondrias, a nivel de la coenzima Q. Aunque no está claro que la toxina murina esté implicada en la patogénesis de la peste humana, los síntomas que produce en el ratón son similares a los que produce en humanos.
Y. pestis también produce una endotoxina altamente inmunogénica que puede dar lugar a una potente respuesta inmune en humanos.
Y. pestis presenta resistencia natural a la penicilina, pero la mayoría de las cepas son sensibles a la estreptomicina, el cloranfenicol y las tetraciclinas. Actualmente hay ciertas evidencias de la sensibilidad de Y. pestis a gentamicina y doxiciclina. Si el tratamiento se inicia rápidamente, la mortalidad de la peste bubónica puede reducirse hasta el 1-5% de los infectados. La peste neumónica y septicémica también puede tratarse, pero suelen progresar tan rápidamente que los antibióticos siempre llegan tarde.
Bacilos Gram (-) no fermentadores
Este gran grupo de bacilos Gram negativos incluye a gérmenes pertenecientes a diferentes familias y otros géneros de incierta clasificación. Pseudomonas, Flavobacterium, Alcaligenes, Acinetobacter, son algunos de ellos, en general desprovistos de grandes atributos de virulencia demostrables, no producen enfermedad en el individuo sano pero pueden comportarse como oportunistas en enfermos inmunodeprimidos. De las numerosas especies de Pseudomonas descritas sólo unas pocas tienen importancia en patología humana. Pseudomonas mallei y P.pseudomallei causan enfermedad severa en el hombre pero se aíslan raramente en el Hemisferio Occidental. Por otra parte P. cepacia es un oportunista poco frecuentemente asociado con enfermedad en el hombre.
Nos referiremos en particular a la especie Pseudomona aeruginosa por su frecuencia en patología humana y estar mejor estudiada que otros. Es un microorganismo versátil, ampliamente distribuido en el suelo, agua, plantas e intestino de animales. Puede causar enfermedad en el hombre, ciertos animales, plantas e insectos. El agua contaminada puede ser una fuente de infección para el hombre. Es susceptible a la desecación, pero sus habilidades metabólicas le permiten sobrevivir y multiplicarse en líquidos y ambientes húmedos de los hospitales. Sus requerimientos nutricionales son variados, se ha aislado P. aeruginosa de aguas termales, e incluso de soluciones desinfectantes en el hospital. Las infecciones humanas están la mayoría restringidas a los pacientes hospitalizados que adquieren el microorganismo de fuentes ambientales (infección exógena) por contacto con vectores humanos o inanimados. P. aeruginosa desarrolla bien en medios simples, utilizándose para su aislamiento los medios de cultivo de uso corriente en el laboratorio clínico. La identificación de cepas de P. aeruginosa típicamente productoras de pigmento no es difícil, pero las cepas no pigmentadas pueden presentar un problema. La mayoría se identifican por la producción de un pigmento, pyocyanina (Bacilo piociánico), soluble en agua, azul, no fluorescente. P. aeruginosa produce además otro pigmento, pyoverdina, soluble en agua, verdeamarillento, fluorescente; otras especies del género Pseudomonas también producen pyoverdina. Otros pigmentos, menos frecuentes pueden ser producidos por P. aeruginosa. La morfología colonial y el olor frutado de aminoacetofenona son elementos de una identificación sencilla, y aunque existen caracteres de identificación confirmatorios, son de uso poco corriente. Son bacilos Gram negativos, rectos o ligeramente curvos, móviles, con un solo flagelo polar. Oxidasa y catalasa positivas, aerobias estrictas, no fermentan glucosa, utilizan diversos azúcares oxidativamente con producción de ácido. Uno de los caracteres más constantes es su capacidad de desarrollar a 42ºC. Producen varias enzimas, proteasas, lipasas, lecitinasas.
Las defensas inespecíficas del huésped son en general suficientes para prevenir la infección por P. aeruginosa, pero brechas en esta barrera permiten a P. aeruginosa invadir y causar infecciones de diversa gravedad. Producen el 10% de las infecciones nosocomiales, infectan heridas y quemaduras y causan infecciones pulmonares, sobre todo neumonía nosocomial e infecciones respiratorias en pacientes con fibrosis quística. La fibrosis quística es una enfermedad genética asociada a un defecto en la secreción de cloro, caracterizada por la producción de mucina con una alteración de su composición iónica, inusualmente espesa. Esto lleva a una menor eficiencia de la mucina para limpiar las bacterias del pulmón y las vías aéreas y puede impedir el movimiento de las células fagocíticas. Estos hechos explican la susceptibilidad de los pacientes con fibrosis quística a la colonización con P. aeruginosa. Si los enfermos son tratados los síntomas pueden desaparecer pero las bacterias permanecen, presentando infecciones recurrentes. Las condiciones del paciente se ven agravadas con la infección a P. aeruginosa por las dificultades terapéuticas que se plantean debido a su alta resistencia a los antimicrobianos.
P. aeruginosa posee los mismos tipos de factores de virulencia que otras bacterias capaces de causar enfermedad en el hombre inmunocompetente. Pero algo interesante es ¿por qué P. aeruginosa no es un patógeno franco y es sólo capaz de producir infecciones oportunistas? Es probable que P. aeruginosa sea ineficiente en su habilidad para llevar a cabo los primeros pasos de la infección; puede colonizar pero no invadir piel y mucosas sanas y tampoco dar infecciones persistentes con producción concomitante de factores tóxicos que dañen los tejidos del huésped. Adhesinas. Produce dos tipos de adhesinas proteicas, pili y adhesinas no pili. Los pili son pili tipo 4 similares a los de N. gonorrhoeae y se parecen también a los pili Tcp de V. cholerae. Permiten a la bacteria adherirse a las células epiteliales, preferentemente a receptores asialo-GM1. P. aeruginosa produce una neuraminidasa que saca los residuos de ácido siálico de GM1, creando sitios de unión para la pilina.
Por otra parte, P. aeruginosa es capaz de unirse a la mucina y lo hace por medio de las adhesinas no pili. Además del gen que codifica para la proteína estructural del pili otros genes codifican proteínas ensambladoras y reguladoras. Exoenzima S. Es una enzima excretada que puede actuar como exotoxina. Tiene actividad de ADPribosilación como otras toxinas, pero aplicada en forma exógena no daña las células del huésped. Al igual que la toxina colérica intervienen proteínas de las células del huésped en la activación de la toxina para lograr su máxima actividad. Se sostiene que actuaría dificultando la acción de los fagocitos lo que facilitaría la sobrevida de P. aeruginosa en el torrente sanguíneo y órganos. En el pulmón actuaría inhibiendo la muerte intrafagocítica de las bacterias y promoviendo la infiltración fagocítica en el área. También puede presentar efecto tóxico directo en los pulmones.
- dominio R (región de unión al receptor celular),
- dominio T (región que media la translocación de la porción enzimática al interior de la célula),
- dominio C (región catalítica).
Los dominios R y T se localizan en la cadena B y el dominio C en la cadena A. La cadena A es enzimáticamente activa por ADPribosilación del factor de elongación 2 (EF-2) de la síntesis proteica, que lo vuelve inactivo. Su receptor es una glicoproteína de las células del hospedero. La mayoría de los aislamientos clínicos la producen, y actuaría produciendo daño en los tejidos y disminuyendo la actividad de los fagocitos. Elastasas. Elastina es el 30% de las proteínas del tejido pulmonar. Está también presente en la pared de los vasos sanguíneos. Es responsable de las propiedades elásticas de estos órganos que se expanden y contraen. P. aeruginosa tiene actividad elastolítica, produce dos enzimas que actuarían concertadamente: LasA y LasB. LasA actuaría clivando la elastina y permitiendo la acción de LasB, que es una zinc metaloproteasa, uno de cuyos sustratos es la elastina.
Estas enzimas actuarían en las etapas tempranas de la enfermedad, por daño directo de los tejidos pero no en infecciones crónicas, debido a la presencia de anticuerpos antielastasas. También pueden intervenir degradando componentes del complemento e inhibidores de 1 proteinasa (inhibe el daño de los tejidos por las proteasas de los polimorfonucleares (PMNs)). En las infecciones crónicas, altos niveles de anticuerpos producidos pueden llevar a la formación de complejos inmunes y su depósito en el pulmón activar complemento y atraer PMNs. Los PMNs producen su propia elastasa, más potente que LasA-LasB. Pequeñas cantidades de LasA pueden facilitar la degradación de la elastina pulmonar causada por la elastasa de los PMNs. Otras enzimas extracelulares. Produce varias enzimas además de las mencionadas. Una lipasa alcalina y dos fosfolipasas, no bien estudiadas. Por otra parte, pyocianina puede funcionar como factor de virulencia. Puede dañar el tejido endotelial in vitro, lo que sugiere una acción in vivo. Un atributo de virulencia muy interesante es la producción de alginato. Es un polímero de ácido mannurónico y gulurónico que forma un gel viscoso alrededor de la bacteria. Las colonias que lo producen tienen aspecto mucoide. Para las bacterias marinas esto es un atributo importante para su supervivencia. P. aeruginosa ha adaptado esto a su supervivencia en el pulmón. En medios de cultivo ricos pierde esta propiedad. Esta capa que rodea a la bacteria y a las colonias de bacterias en el pulmón puede actuar como adhesina y probablemente previene la ingestión fagocítica de la bacteria. Los genes que intervienen en su codificación están agrupados en un sector del cromosoma y organizados en un operón, poseen un sistema de regulación extremadamente complejo. El LPS también varía durante la transición mucoide – no mucoide. En cepas no mucoides el antígeno O del LPS tiene cadenas largas y carga negativa mientras que las cepas mucoides tienen cadenas más cortas y una composición de azúcares que lo hacen mucho más neutro; esto sería importante en la alta resistencia a algunos antibióticos que presenta P. aeruginosa, situación problemática en pacientes internados, pero dramática en los pacientes con fibrosis quística, que muchas veces presentan infecciones por P. aeruginosa resistente a todos los antibióticos disponibles.
Género Hafnia
A éste último grupo de enterobacterias me gusta llamarlas "las figuritas difíciles del álbum" pues son raras de encontrar y de aislar. Hafnia alvei es un bacilo gram negativo, única especie del género Hafnia, de la familia Enterobacteriaceae, y que durante mucho tiempo fue incluida en el género Enterobacter, hasta el desarrollo de las técnicas de biología molecular, que determinaron su separación, con definición de un nuevo género. Se encuentra ampliamente disperso en la naturaleza, en lugares como aguas residuales, suelo, oro – faringe humana, intestino delgado y heces de personas y animales siendo habitualmente un microorganismo colonizador. Se trata de un microorganismo facultativo, usualmente no patógeno, que se ha aislado de cultivos orgánicos (faringe, bronquio, sangre, orina y heces), produciendo infecciones en la gran mayoría de los casos, en pacientes con enfermedad crónica de base, inmunodeprimidos y en relación con estancias hospitalarias y utilización de antibioticoterapia de amplio espectro. En los casos descriptos en la literatura el aislamiento de Hafnia alvei se asocia a flora polimicrobiana, siendo difícil establecer su implicación como agente causal. En la bibliografía revisada (MEDLINE de los últimos 10 años) se han descrito casos de gastroenteritis, enterocolitis necrotizante, colecistitis piógena, peritonitis, meningitis, infecciones del tracto urinario, abscesos cutáneos, endoftalmitis, bacteriemias, endocarditis, neumonía, empiema e infecciones de heridas en enfermos hospitalizados. H. alvei es un bacilo cuyo nombre es enterobacter hafniae y puede ser responsable de infecciones graves adquiridas en la comunidad o en el hospital, constituyendo Enterobacter y Hafnia, agentes de infección nosocomial en el 5% de los casos. En adultos se considera una causa excepcional de bacteremia, neumonía, infección nosocomial de tejidos blandos, colonización de catéteres centrales, infección postransplante, endocarditis protésica, septicemia con shock y coagulación intravascular diseminada. Esto es así porque los sujetos con infección por H. alvei, excepto aquéllos con afectación intestinal, suelen tener una enfermedad grave de base, enfermedad pulmonar obstructiva crónica, diabetes mellitus, insuficiencia renal crónica, cáncer o una serología VIH positiva.
Género Ewingella
Ewingella, previamente conocido como Grupo Entérico 40, es un nuevo género en la familia de Enterobacteriaceae y se describió primero por Grimont y colaboradores en 1983. Este género incluye sólo una especie, la Ewingella americana. Este microorganismo raramente se encuentra en las muestras clínicas humanas. La fuente más común ha sido sangre, pero también se ha aislado del esputo, orina y heridas. En la mayoría de los casos, la importancia de la patogenia de este organismo, aunque sugestivo, no se ha establecido. Recientemente, informes esparcidos de infecciones debidas a E. americana han aparecido en la literatura. Ahora es más frecuente observar su desarrollo en peritonitis causado por E. americana en pacientes con fases finales de enfermedad renal que sufren la diálisis peritoneal ambulante continua desde hace más de 12 años. La causa primaria de fracaso renal era la enfermedad del riñón poliquístico.
Género Kluyvera
Kluyvera corresponde a un nuevo género llamado: Grupo Entérico 8. Se divide en tres grupos:
• Kluyvera ascorbata, que sería la especie tipo y que se aísla preferentemente de especímenes clínicos, es incapaz de crecer a 5º C, e in vitro es inhibida por cefalotina y carbenicilina. Es test de ascorbato positivo a diferencia de la segunda especie,
• Kluyvera cryocrescens que es negativa ante este test y que se aísla más del medio ambiente que del paciente.
• Finalmente existe un grupo heterogéneo, sin nombre específico llamado Kluyvera especie grupo tres, distinto genéticamente de los anteriores.
Las cepas de Kluyvera tienen las mismas características de la familia Enterobacteriaceae a la cual pertenecen, son bacilos Gram (-) con flagelos perítricos lo que la hacen móviles, catalasa (+) y oxidasa (-), crecen en agar de Macconkey, fermentan la glucosa y son indol (+), rojo metilo (+). Vogues Proskauer (-), citrato (+), H2S (-), ureasa (-), fenilalanina deaminasa (-) y arginina dihidrolasa (-), lisina (+) y ornitina descarboxilasa (+). Es difícil diferenciarlas de Escherichia coli. Según resultados a través del Microscan, pudimos apreciar que es una colonia más seca y rugosa y con un fenotipo de mayor resistencia a antimicrobianos que E. coli. Todavía se requiere mayor información para que podamos adjudicarle un significado clínico a este género.
Género Cedecea
Cedecea davisae es un bacilo gramnegativo, que pertenece a la familia de las Enterobacteriaceae; aunque tiene diferencias fenotípicas con los otros microorganismos de esta familia de bacterias, tiene grandes similitudes con la Serratia. Es lipasa positiva, siendo resistente a la acción antimicrobiana de algunas cefalosporinas y de la colistina. Se han comunicado aislamientos por este infrecuente microorganismo en esputo, tracto gastrointestinal, heridas de las manos, escroto y ojos y también se ha aislado en algunos casos de bacteriemias. No se ha encontrado a la fecha ningún caso de absceso de puerta de entrada de laparoscopia en el que se haya aislado este microorganismo, pero no es de extrañar que sea un oportunista en éste tipo de técnicas quirúrgicas. El nombre de Cedecea fue propuesto recientemente para un único nuevo género en el ancho mundo de las Enterobacteriaceae, previamente conocido como Grupo Entérico 15. Los extendidos de Cedecea se parecen a los de Serratia porque ellos son lipasas positivas y resistentes al cephalothin y colistin. Sin embargo, Serratia difiere de Cedecea al no hidrolizar la gelatina y el ADN. Dos especies se nombraron originalmente en Cedecea: C. davisae y C. lapagei, pero la hibridación de ADN indicó que otro grupo era distinto y debe ser considerado entonces como un tercero adicional.
Género Moellerella
El nombre de Moellerella wisconsensis se propone previamente para un grupo de la familia Enterobacteriaceae llamado los Grupos Entéricos 46. La especie wisconsensis se acuñó porque se aislaron seis de las nueve especies reconocidas en Wisconsin (USA). Estas especies de wisconsensis eran negativas para: la producción del indol, Voges – Proskauer, producción de SH2, urea, deaminasa de la felilalanina, lisina y decarboxilasa de la ornitina, dihidrolasa de la arginina, la producción de gas de la D – glucosa, la producción ácida de la trealosa y la motilidad. En cambio, eran positivas para: el rojo de metilo, citrato (Simmons), producción ácida de la lactosa y rafinosa y resistente al colistin. La información clínica sobre un caso de un paciente internado encontrado en USA puede a priori ser asociado con un caso de diarrea del mismo no por su patogenicidad sino por su oportunismo. En el agar de MacConkey, las colonias de M. wisconsensis eran luminosas y rojas con la bilis precipitada alrededor de ellos y así eran indistinguible de las colonias de Escherichia coli. Los estudios futuros deben enfocar en el aislamiento de este nuevo organismo y su relación a la enfermedad humana, por sobre todo a la trasmisión por los alimentos (ETA).
Género Rahnella
Entre los cambios que ha experimentado el trabajo con bacterias y hongos tenemos los adelantos en la identificación, que ha pasa o rápidamente manual a automatizada, lo que ha permitido crear una serie de bases de datos con las cuales se aumentan las posibilidades de identificación correcta de un organismo. La primera de esas bases de datos es la utilizada por el sistema API de la Casa BioMerieux, la cual ha mejorado e introducido una serie de nuevos organismos. Esta misma base de datos se utiliza en los sistemas automatizados como el Vitek de la misma casa comercial y otras bases de datos de características similares se emplean en sistemas como el MicroScan de la Casa Dade. Unido a esta mejoría en la identificación de los microorganismos y como un paso más adelante, está el hecho de que el futuro en la clasificación de los microorganismos parece dirigirse al uso de los métodos moleculares, ya sea PCR o hibridización. Este futuro ya casi está entre nosotros y técnicas como el ribotipeo o técnicas para la detección de genes de resistencia bacterianos ya son de uso en algunos laboratorios de investigación.
Todo esto ha permitido ampliar la gama de organismos que los laboratorios clínicos pueden identificar, entre ellos los de muy baja frecuencia de aislamiento a nivel mundial, como es el caso de la Rahnella aquatilis que es un raro bacilo Gram negativo que pertenece a la familia Enterobacteriaceae y fue aislado por primera vez en 1979. Ha sido aislado principalmente de agua fresca y los aislamientos clínicos son sumamente escasos. Ha sido encontrado en el catéter de un paciente con bacteremia posterior a un transplante de médula ósea, en orinas de pacientes que han recibido un transplante renal, en heridas quirúrgicas infectadas, en sangre, en muestras respiratorias y en heces. Algunos de estos pacientes estaban infectados con el virus de la inmunodeficiencia adquirida. Es importante mencionar que dada la rareza de los aislamientos de Rahnella aquatilis en muestras humanas, no es posible establecer, con algún grado de certeza, su verdadera capacidad patogénica.
"SOMOS LO QUE HACEMOS REPETIDAMENTE. EXCELENCIA, POR LO TANTO, NO ES UN ACTO SINO UN HÁBITO"
ARISTOTELES
LEGALES: El autor no asume responsabilidad alguna por la descarga, copia, distribución, modificación o alteración de los contenidos publicados, sean propios del mismo o de terceros, los cuales pudieren estar protegidos por Copyright, Derechos de Propiedad Intelectual, Derechos de Autor, o relacionados. La Bibliografía del tema expuesto y el crédito fotográfico está en poder del Autor y no se publica dada su extensión, pero se enviará por mail al interesado que la solicitare debidamente fundamentada.